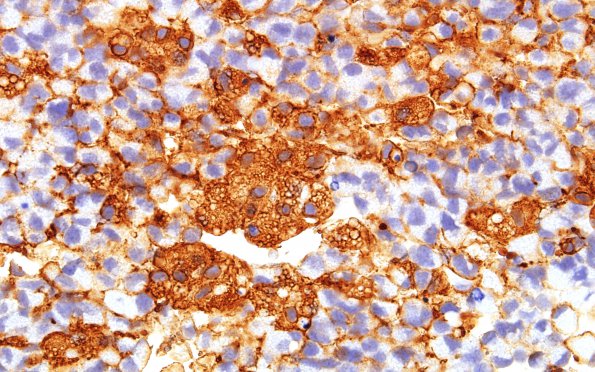
2B5 Glioblastoma, granular cell type (Case 2) GFAP 60X 1

Table of Contents
Washington University Experience | NEOPLASMS (GLIAL) | Glioblastoma, granular cell type | 2B5 Glioblastoma, granular cell type (Case 2) GFAP 60X 1
Although tumor cells are GFAP immunoreactive, the granules themselves are not GFAP immunoreactive. (GFAP IHC)